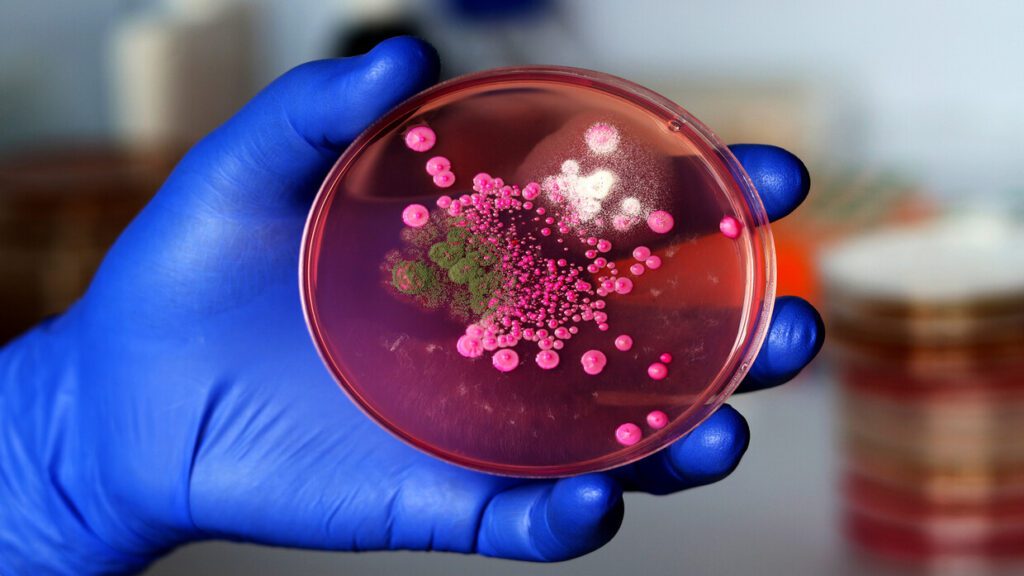
اكتشاف عدوى فطرية جديدة في الصين قادرة على إصابة البشر

اكتشف علماء في الصين عدوى فطرية لم تكن معروفة من قبل، قادرة على إصابة البشر، ويمكنها البقاء على قيد الحياة داخل جسم الإنسان وتصبح أكثر مقاومة للأدوية عند تعرضها لدرجات حرارة أعلى.
وعثر على الفطر، المسمى Rhodosporidiobolus Fluvialis، أو اختصارا R.fluvialis، في عينات سريرية من مريضين غير متصلين بالمستشفى.
وفي التجارب، وجد العلماء أن الفطر كان مقاوما للعديد من العقارات الشائعة المضادة للفطريات عند درجات حرارة أعلى، قريبة من درجة حرارة جسم الإنسان.
وأدت درجة الحرارة هذه إلى ظهور “طفرات شديدة الضراوة” قادرة على التسبب في مرض أكثر خطورة في فئران المختبر.
وكتب العلماء في تقرير نشر في 19 يونيو في مجلة Nature Microbiology أن النتائج “تدعم فكرة أن ظاهرة الاحتباس الحراري يمكن أن تعزز تطور مسببات الأمراض الفطرية الجديدة”.
وتوصل الفريق إلى هذا الاكتشاف بعد فحص عينات من الفطريات من المرضى في 96 مستشفى في جميع أنحاء الصين بين عامي 2009 و2019.
وإجمالا، تم جمع وتحليل 27100 سلالة من الفطريات، ومن بين هذه الأنواع، لم يتم رؤية سوى R.fluvialis في البشر من قبل.
وتم الكشف عن R.fluvialis في دم اثنين من المرضى غير المتصلين ببعضهم. وبالإضافة إلى إصابتهم بالفطر، كان لديهم حالات صحية خطيرة.
وكان أحد المرضى يبلغ من العمر 61 عاما وتوفي في وحدة العناية المركزة (ICU) في نانجينغ في عام 2013، والآخر يبلغ من العمر 85 عاما وتوفي في عام 2016 بعد علاجه في وحدة العناية المركزة في تيانجين. ولا يشير التقرير إلى ما إذا كانت العدوى الفطرية ساهمت بشكل مباشر في وفاة هؤلاء المرضى أو إذا كانوا قد أصيبوا بالعدوى في ذلك الوقت.
وكجزء من علاجهم، تم إعطاء المرضى أدوية مضادة للفطريات شائعة، بما في ذلك “الفلوكونازول” و”الكاسبوفونجين”.
ووجدت الدراسات المعملية التي أجراها الفريق لاحقا أن بكتيريا R.fluvialis مقاومة لهذين العقارين.
وقال ديفيد دينينغ، أستاذ الأمراض المعدية بجامعة مانشستر بالمملكة المتحدة، والذي لم يشارك في البحث، لمجلة Science، إن هذه النتيجة “تنبأ بالسوء للمستقبل”.
ولكن بالنسبة إلى R. Fluvialis، على وجه التحديد، فإن بعض العلماء يجادلون ضد الاستنتاجات المثيرة للقلق، حيث يقول ماثيو فيشر، أستاذ علم وبائيات الأمراض الفطرية في إمبريال كوليدج لندن والذي لم يشارك في البحث، لمجلة Science إنه لا ينبغي حتى الآن النظر إلى الفطر على أنها تهديد كبير وناشئ.
مضيفا: “شعوري الأول هنا هو أن هناك بيئات لم يتم فحصها في الصين حيث تعيش هذه الخمائر، وأن هذين المريضين لم يحالفهما الحظ بالتعرض لها. باختصار، لا يوجد دليل على انتشار R.fluvialis على نطاق واسع بين السكان، على الرغم من سماته المثيرة للقلق”.